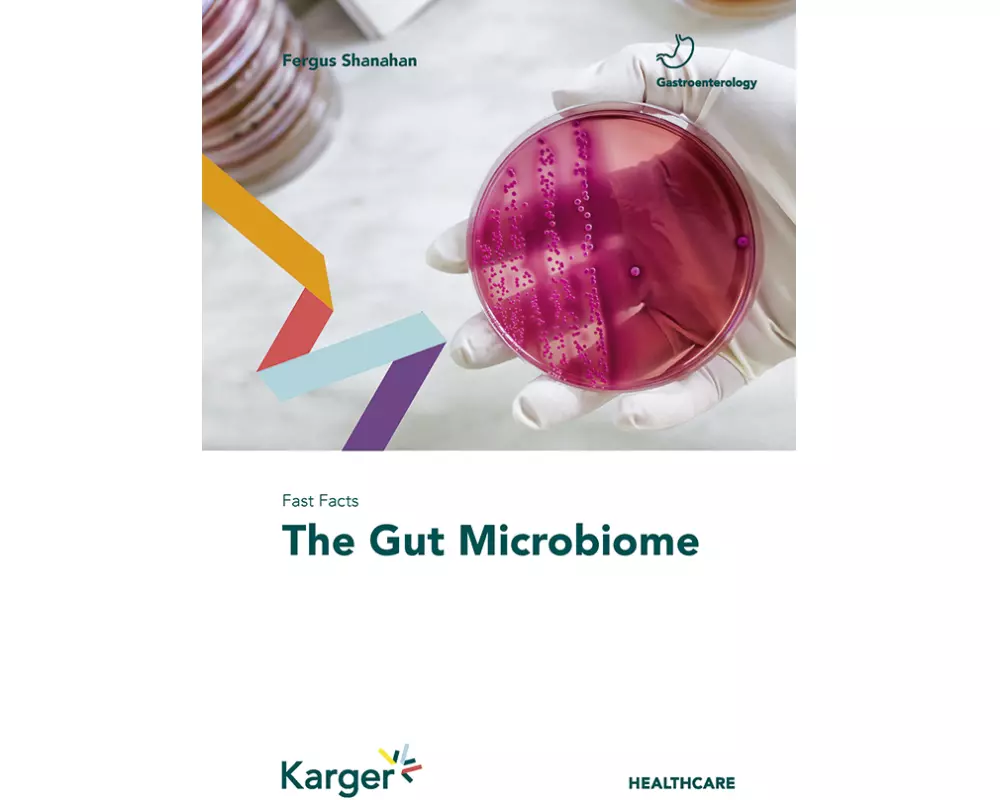
Fast Facts: The Gut Microbiome

Marke: Karger, S
Hier finden Sie zu den besten Preisen alle Produkte der Marke Karger, S.
Bestellungen bis 17:00 Uhr für Produkte auf Lager erhalten Sie - ohne Versandgebühr - am nächsten Werktag.
1
Meistgekauft
Auf Lager:
3
Break Free - Eigenständig werden mit Diabetes Typ 1
Wie kleine Diabetesheld*innen groß werden. Für Eltern von Diabeteskindern im Grundschulalter
CHF 31.50
2
Meistgekauft
Erhältlich:
Nicht auf Lager
Metabolic Syndrome Consequent to Endocrine Disorders
-18.1 %
CHF 125.20
3
Meistgekauft
Auf Lager:
2
Molar Incisor Hypomineralisation: New Perceptions
-13.4 %
CHF 177.53
5
Erhältlich:
Nicht auf Lager
GH Excess and Deficiency from Fetus to Older Age
A Kaleidoscopic Overview
CHF 188.–